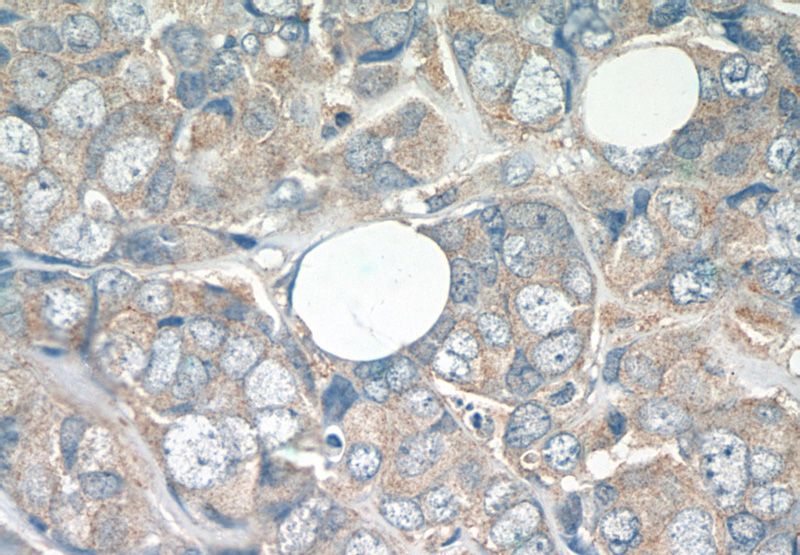
Immunohistochemistry of paraffin-embedded human breast cancer tissue slide using Catalog No:108284(ATF2-Specific Antibody) at dilution of 1:50 (under 40x lens)

-
Product Name
ATF2-Specific antibody
- Documents
-
Description
ATF2-Specific Rabbit Polyclonal antibody. Positive WB detected in HeLa cells. Positive IHC detected in human breast cancer tissue. Observed molecular weight by Western-blot: 70kd
-
Tested applications
ELISA, WB, IHC
-
Species reactivity
Human,Mouse,Rat; other species not tested.
-
Alternative names
ATF2 antibody; CRE BP1 antibody; CREB 2 antibody; CREB2 antibody; CREBP1 antibody; HB16 antibody; TREB7 antibody
-
Isotype
Rabbit IgG
-
Preparation
This antibody was obtained by immunization of Peptide (Accession Number: NM_001256094). Purification method: Antigen affinity purified.
-
Clonality
Polyclonal
-
Formulation
PBS with 0.02% sodium azide and 50% glycerol pH 7.3.
-
Storage instructions
Store at -20℃. DO NOT ALIQUOT
-
Applications
Recommended Dilution:
WB: 1:200-1:2000
IHC: 1:20-1:200
-
Validations

HeLa cells were subjected to SDS PAGE followed by western blot with Catalog No:108284(ATF2-Specific antibody) at dilution of 1:600
Immunohistochemistry of paraffin-embedded human breast cancer tissue slide using Catalog No:108284(ATF2-Specific Antibody) at dilution of 1:50 (under 40x lens)
-
Background
ATF2, also named as CREB2 and CREBP1, contains one bZIP domain and one C2H2-type zinc finger. It belongs to the bZIP family. ATF2 binds to the cAMP-responsive element(CRE), an octameric palindrome. It forms a homodimer or a heterodimer with c-Jun and stimulates CRE-dependent transcription. It is also a histone acetyltransferase (HAT) that specifically acetylates histones H2B and H4 in vitro; thus it may represent a class of sequence-specific factors that activate transcription by direct effects on chromatin components. ATF2 binds DNA as a dimer and can form a homodimer in the absence of DNA. It binds through its N-terminal region to UTF1 which acts as a coactivator of ATF2 transcriptional activity. This antibody is a rabbit polyclonal antibody raised against a peptide mapping within human ATF2.
-
References
- Zhao F, Xu G, Zhou Y. MicroRNA-26b inhibits hepatitis B virus transcription and replication by targeting the host factor CHORDC1 protein. The Journal of biological chemistry. 289(50):35029-41. 2014.
Related Products / Services
Please note: All products are "FOR RESEARCH USE ONLY AND ARE NOT INTENDED FOR DIAGNOSTIC OR THERAPEUTIC USE"
